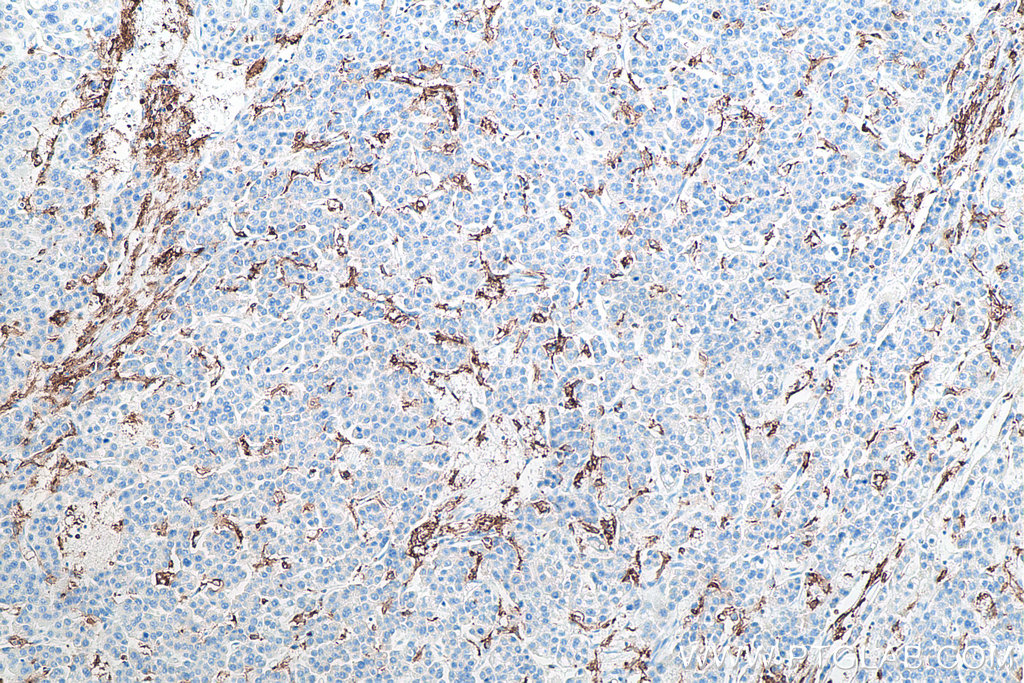

IHCeasy® CD11c Ready-To-Use IHC Kit
CD11c Ready-to-use reagent kit for IHC.
Cat no : KHC0017
Synonyms
CD11C, Integrin alpha X, ITGAX, Leu M5, SLEB6
Validation Data Gallery
Product Information
KHC0017 is a ready-to-use IHC kit for staining of CD11c(Integrin alpha X). The kit provides all reagents, from antigen retrieval to cover slip mounting, that require little to no diluting or handling prior to use. Simply apply the reagents to your sample slide according to the protocol and you're steps away from obtaining high-quality IHC data.
| Product name | IHCeasy CD11c Ready-To-Use IHC Kit |
| Sample type | FFPE tissue |
| Assay type | Immunohistochemistry |
| Primary antibody type | Mouse Monoclonal |
| Secondary antibody type | Polymer-HRP-Goat anti-Mouse |
| Reactivity | Human |
Kit components
| Component | Size | Concentration |
|---|---|---|
| Antigen Retrieval Buffer | 100 mL | 50× |
| Washing Buffer | 100 mL ×2 | 20× |
| Blocking Buffer | 5 mL | RTU |
| Primary Antibody | 5 mL | RTU |
| Secondary Antibody | 5 mL | RTU |
| Chromogen Component A | 0.2 mL | RTU |
| Chromogen Component B | 4 mL | RTU |
| Signal Enhancer | 5 mL | RTU |
| Counter Staining Reagent | 5 mL | RTU |
| Mounting Media | 5 mL | RTU |
| Datasheet | 1 Copy | |
| Manual | 1 Copy |
Background Information
Integrins are cell adhesion receptors that are heterodimers composed of non-covalently associated α and β subunits. CD11c/Integrin alpha X is a 145-150 kDa type I transmembrane glycoprotein present on a variety of cells, including monocytes/macrophages, granulocytes, NK cells and dendritic cells. Integrin alpha X/beta 2 acts a receptor for fibrinogen and is important in monocyte adhesion and chemotaxis.
Properties
| Storage Instructions | All the reagents are stored at 2-8°C. The kit is stable for 6 months from the date of receipt. |
| Synonyms | CD11C, Integrin alpha X, ITGAX, Leu M5, SLEB6 |
Publications
| Application | Title |
|---|---|
J Invest Dermatol The Clinical and Molecular Response of Pyoderma Gangrenosum to Interleukin 23 Blockade: Result from a proof-of-concept open-label clinical trial | |
Exp Dermatol Baseline clinical, hormonal and molecular markers associated with clinical response to IL-23 antagonism in hidradenitis suppurativa: A prospective cohort study |